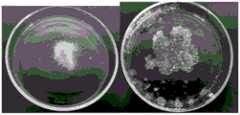

CN112263563A - Hydrogel with bowel relaxing function and preparation method and application thereof - Google Patents
Hydrogel with bowel relaxing function and preparation method and application thereofDownload PDFInfo
- Publication number
- CN112263563A CN112263563ACN202011207960.7ACN202011207960ACN112263563ACN 112263563 ACN112263563 ACN 112263563ACN 202011207960 ACN202011207960 ACN 202011207960ACN 112263563 ACN112263563 ACN 112263563A
- Authority
- CN
- China
- Prior art keywords
- hydrogel
- crosslinking
- colon
- acid
- water
- Prior art date
- Legal status (The legal status is an assumption and is not a legal conclusion. Google has not performed a legal analysis and makes no representation as to the accuracy of the status listed.)
- Pending
Links
- 239000000017hydrogelSubstances0.000titleclaimsabstractdescription107
- 230000002040relaxant effectEffects0.000titleclaimsabstractdescription17
- 238000002360preparation methodMethods0.000titleclaimsabstractdescription15
- 238000004132cross linkingMethods0.000claimsabstractdescription54
- XLYOFNOQVPJJNP-UHFFFAOYSA-NwaterSubstancesOXLYOFNOQVPJJNP-UHFFFAOYSA-N0.000claimsabstractdescription47
- DPXJVFZANSGRMM-UHFFFAOYSA-Nacetic acid;2,3,4,5,6-pentahydroxyhexanal;sodiumChemical compound[Na].CC(O)=O.OCC(O)C(O)C(O)C(O)C=ODPXJVFZANSGRMM-UHFFFAOYSA-N0.000claimsabstractdescription35
- 239000001768carboxy methyl celluloseSubstances0.000claimsabstractdescription34
- 235000019812sodium carboxymethyl celluloseNutrition0.000claimsabstractdescription34
- 229920001027sodium carboxymethylcellulosePolymers0.000claimsabstractdescription34
- 239000002253acidSubstances0.000claimsabstractdescription13
- 239000002775capsuleSubstances0.000claimsabstractdescription12
- 238000006243chemical reactionMethods0.000claimsabstractdescription9
- 239000002994raw materialSubstances0.000claimsabstractdescription8
- 238000000034methodMethods0.000claimsabstractdescription7
- 230000008569processEffects0.000claimsabstractdescription5
- 239000000693micelleSubstances0.000claimsdescription16
- 239000000243solutionSubstances0.000claimsdescription14
- 239000002245particleSubstances0.000claimsdescription13
- 238000003756stirringMethods0.000claimsdescription10
- BJEPYKJPYRNKOW-REOHCLBHSA-N(S)-malic acidChemical compoundOC(=O)[C@@H](O)CC(O)=OBJEPYKJPYRNKOW-REOHCLBHSA-N0.000claimsdescription9
- BJEPYKJPYRNKOW-UHFFFAOYSA-Nalpha-hydroxysuccinic acidNatural productsOC(=O)C(O)CC(O)=OBJEPYKJPYRNKOW-UHFFFAOYSA-N0.000claimsdescription9
- 238000001035dryingMethods0.000claimsdescription9
- 239000001630malic acidSubstances0.000claimsdescription9
- 235000011090malic acidNutrition0.000claimsdescription9
- 238000006467substitution reactionMethods0.000claimsdescription7
- KRKNYBCHXYNGOX-UHFFFAOYSA-Ncitric acidChemical compoundOC(=O)CC(O)(C(O)=O)CC(O)=OKRKNYBCHXYNGOX-UHFFFAOYSA-N0.000claimsdescription6
- 239000007864aqueous solutionSubstances0.000claimsdescription5
- 230000002475laxative effectEffects0.000claimsdescription5
- VZCYOOQTPOCHFL-OWOJBTEDSA-NFumaric acidChemical compoundOC(=O)\C=C\C(O)=OVZCYOOQTPOCHFL-OWOJBTEDSA-N0.000claimsdescription4
- 239000008141laxativeSubstances0.000claimsdescription3
- FEWJPZIEWOKRBE-JCYAYHJZSA-NDextrotartaric acidChemical compoundOC(=O)[C@H](O)[C@@H](O)C(O)=OFEWJPZIEWOKRBE-JCYAYHJZSA-N0.000claimsdescription2
- KDYFGRWQOYBRFD-UHFFFAOYSA-NSuccinic acidNatural productsOC(=O)CCC(O)=OKDYFGRWQOYBRFD-UHFFFAOYSA-N0.000claimsdescription2
- FEWJPZIEWOKRBE-UHFFFAOYSA-NTartaric acidNatural products[H+].[H+].[O-]C(=O)C(O)C(O)C([O-])=OFEWJPZIEWOKRBE-UHFFFAOYSA-N0.000claimsdescription2
- KDYFGRWQOYBRFD-NUQCWPJISA-Nbutanedioic acidChemical compoundO[14C](=O)CC[14C](O)=OKDYFGRWQOYBRFD-NUQCWPJISA-N0.000claimsdescription2
- 235000015165citric acidNutrition0.000claimsdescription2
- 239000001530fumaric acidSubstances0.000claimsdescription2
- 235000011087fumaric acidNutrition0.000claimsdescription2
- 239000011975tartaric acidSubstances0.000claimsdescription2
- 235000002906tartaric acidNutrition0.000claimsdescription2
- VZCYOOQTPOCHFL-UHFFFAOYSA-Ntrans-butenedioic acidNatural productsOC(=O)C=CC(O)=OVZCYOOQTPOCHFL-UHFFFAOYSA-N0.000claimsdescription2
- 235000011389fruit/vegetable juiceNutrition0.000abstractdescription26
- 210000001072colonAnatomy0.000abstractdescription22
- 210000004051gastric juiceAnatomy0.000abstractdescription17
- 230000000694effectsEffects0.000abstractdescription13
- 210000000813small intestineAnatomy0.000abstractdescription13
- 238000010521absorption reactionMethods0.000abstractdescription6
- 230000007935neutral effectEffects0.000abstractdescription5
- 230000002378acidificating effectEffects0.000abstractdescription4
- 230000035945sensitivityEffects0.000abstractdescription2
- 230000008961swellingEffects0.000description21
- 238000012360testing methodMethods0.000description12
- 206010010774ConstipationDiseases0.000description11
- 239000007788liquidSubstances0.000description10
- 230000000968intestinal effectEffects0.000description9
- 239000003814drugSubstances0.000description7
- 239000012530fluidSubstances0.000description7
- 210000000936intestineAnatomy0.000description7
- 210000002784stomachAnatomy0.000description7
- 230000002522swelling effectEffects0.000description7
- HEMHJVSKTPXQMS-UHFFFAOYSA-MSodium hydroxideChemical compound[OH-].[Na+]HEMHJVSKTPXQMS-UHFFFAOYSA-M0.000description6
- 210000001035gastrointestinal tractAnatomy0.000description6
- 125000003178carboxy groupChemical group[H]OC(*)=O0.000description5
- -1semen plantaginisSubstances0.000description5
- 229920000148Polycarbophil calciumPolymers0.000description4
- 230000000112colonic effectEffects0.000description4
- 230000013872defecationEffects0.000description4
- 235000013402health foodNutrition0.000description4
- 238000005303weighingMethods0.000description4
- 229940095498calcium polycarbophilDrugs0.000description3
- 238000010382chemical cross-linkingMethods0.000description3
- 235000013305foodNutrition0.000description3
- 210000004211gastric acidAnatomy0.000description3
- 238000010438heat treatmentMethods0.000description3
- 239000001257hydrogenSubstances0.000description3
- 229910052739hydrogenInorganic materials0.000description3
- LWIHDJKSTIGBAC-UHFFFAOYSA-Kpotassium phosphateSubstances[K+].[K+].[K+].[O-]P([O-])([O-])=OLWIHDJKSTIGBAC-UHFFFAOYSA-K0.000description3
- 210000000582semenAnatomy0.000description3
- 238000000967suction filtrationMethods0.000description3
- 208000037147HypercalcaemiaDiseases0.000description2
- 108010019160PancreatinProteins0.000description2
- 206010000496acneDiseases0.000description2
- 239000008186active pharmaceutical agentSubstances0.000description2
- 230000009286beneficial effectEffects0.000description2
- 230000015556catabolic processEffects0.000description2
- 238000006482condensation reactionMethods0.000description2
- 238000005520cutting processMethods0.000description2
- 238000006731degradation reactionMethods0.000description2
- 238000010494dissociation reactionMethods0.000description2
- 230000005593dissociationsEffects0.000description2
- 238000000227grindingMethods0.000description2
- 241000411851herbal medicineSpecies0.000description2
- 239000001866hydroxypropyl methyl celluloseSubstances0.000description2
- 235000010979hydroxypropyl methyl celluloseNutrition0.000description2
- 229920003088hydroxypropyl methyl cellulosePolymers0.000description2
- UFVKGYZPFZQRLF-UHFFFAOYSA-Nhydroxypropyl methyl celluloseChemical compoundOC1C(O)C(OC)OC(CO)C1OC1C(O)C(O)C(OC2C(C(O)C(OC3C(C(O)C(O)C(CO)O3)O)C(CO)O2)O)C(CO)O1UFVKGYZPFZQRLF-UHFFFAOYSA-N0.000description2
- 230000000148hypercalcaemiaEffects0.000description2
- 208000030915hypercalcemia diseaseDiseases0.000description2
- 210000002429large intestineAnatomy0.000description2
- 230000007774longtermEffects0.000description2
- 229910000402monopotassium phosphateInorganic materials0.000description2
- 235000019796monopotassium phosphateNutrition0.000description2
- 229940055695pancreatinDrugs0.000description2
- 230000008855peristalsisEffects0.000description2
- GNSKLFRGEWLPPA-UHFFFAOYSA-Mpotassium dihydrogen phosphateChemical compound[K+].OP(O)([O-])=OGNSKLFRGEWLPPA-UHFFFAOYSA-M0.000description2
- 230000002035prolonged effectEffects0.000description2
- 238000011160researchMethods0.000description2
- 238000012216screeningMethods0.000description2
- 239000000126substanceSubstances0.000description2
- 208000002874Acne VulgarisDiseases0.000description1
- 235000017166Bambusa arundinaceaNutrition0.000description1
- 235000017491Bambusa tuldaNutrition0.000description1
- 244000025596Cassia laevigataSpecies0.000description1
- 235000006693Cassia laevigataNutrition0.000description1
- 206010008570ChloasmaDiseases0.000description1
- 239000009636Huang QiSubstances0.000description1
- VEXZGXHMUGYJMC-UHFFFAOYSA-NHydrochloric acidChemical compoundClVEXZGXHMUGYJMC-UHFFFAOYSA-N0.000description1
- 206010025421MaculeDiseases0.000description1
- 208000003351MelanosisDiseases0.000description1
- 235000003805Musa ABB GroupNutrition0.000description1
- 240000008790Musa x paradisiacaSpecies0.000description1
- 102000057297Pepsin AHuman genes0.000description1
- 108090000284Pepsin AProteins0.000description1
- 244000082204Phyllostachys viridisSpecies0.000description1
- 235000015334Phyllostachys viridisNutrition0.000description1
- 235000015266Plantago majorNutrition0.000description1
- 244000299790Rheum rhabarbarumSpecies0.000description1
- 235000009411Rheum rhabarbarumNutrition0.000description1
- UQZIYBXSHAGNOE-USOSMYMVSA-NStachyoseNatural productsO(C[C@H]1[C@@H](O)[C@H](O)[C@H](O)[C@@H](O[C@@]2(CO)[C@H](O)[C@@H](O)[C@@H](CO)O2)O1)[C@@H]1[C@H](O)[C@@H](O)[C@@H](O)[C@H](CO[C@@H]2[C@@H](O)[C@@H](O)[C@@H](O)[C@H](CO)O2)O1UQZIYBXSHAGNOE-USOSMYMVSA-N0.000description1
- 229930003316Vitamin DNatural products0.000description1
- QYSXJUFSXHHAJI-XFEUOLMDSA-NVitamin D3Natural productsC1(/[C@@H]2CC[C@@H]([C@]2(CCC1)C)[C@H](C)CCCC(C)C)=C/C=C1\C[C@@H](O)CCC1=CQYSXJUFSXHHAJI-XFEUOLMDSA-N0.000description1
- TVXBFESIOXBWNM-UHFFFAOYSA-NXylitolNatural productsOCCC(O)C(O)C(O)CCOTVXBFESIOXBWNM-UHFFFAOYSA-N0.000description1
- 230000005856abnormalityEffects0.000description1
- 150000007513acidsChemical class0.000description1
- 230000009471actionEffects0.000description1
- 239000002671adjuvantSubstances0.000description1
- 239000011425bambooSubstances0.000description1
- 230000015572biosynthetic processEffects0.000description1
- 235000021329brown riceNutrition0.000description1
- 229920003123carboxymethyl cellulose sodiumPolymers0.000description1
- 229940063834carboxymethylcellulose sodiumDrugs0.000description1
- 239000007795chemical reaction productSubstances0.000description1
- 230000001684chronic effectEffects0.000description1
- 230000001276controlling effectEffects0.000description1
- 239000003431cross linking reagentSubstances0.000description1
- 230000007547defectEffects0.000description1
- 230000007812deficiencyEffects0.000description1
- 238000011161developmentMethods0.000description1
- ZPWVASYFFYYZEW-UHFFFAOYSA-Ldipotassium hydrogen phosphateChemical compound[K+].[K+].OP([O-])([O-])=OZPWVASYFFYYZEW-UHFFFAOYSA-L0.000description1
- 229910000396dipotassium phosphateInorganic materials0.000description1
- 235000019797dipotassium phosphateNutrition0.000description1
- 238000004090dissolutionMethods0.000description1
- 229940079593drugDrugs0.000description1
- 230000004064dysfunctionEffects0.000description1
- 125000004185ester groupChemical group0.000description1
- 238000001704evaporationMethods0.000description1
- 230000008020evaporationEffects0.000description1
- 230000003631expected effectEffects0.000description1
- 239000000284extractSubstances0.000description1
- 230000002349favourable effectEffects0.000description1
- 210000003608feceAnatomy0.000description1
- 230000002496gastric effectEffects0.000description1
- 230000007062hydrolysisEffects0.000description1
- 238000006460hydrolysis reactionMethods0.000description1
- 229920001477hydrophilic polymerPolymers0.000description1
- 125000002887hydroxy groupChemical group[H]O*0.000description1
- 208000028774intestinal diseaseDiseases0.000description1
- 230000007413intestinal healthEffects0.000description1
- 230000001788irregularEffects0.000description1
- 208000002551irritable bowel syndromeDiseases0.000description1
- 210000003734kidneyAnatomy0.000description1
- 238000004519manufacturing processMethods0.000description1
- 235000012054mealsNutrition0.000description1
- HEBKCHPVOIAQTA-UHFFFAOYSA-Nmeso ribitolNatural productsOCC(O)C(O)C(O)COHEBKCHPVOIAQTA-UHFFFAOYSA-N0.000description1
- 208000030159metabolic diseaseDiseases0.000description1
- 238000002156mixingMethods0.000description1
- 238000012986modificationMethods0.000description1
- 230000004048modificationEffects0.000description1
- 210000003097mucusAnatomy0.000description1
- 231100000957no side effectToxicity0.000description1
- 229940111202pepsinDrugs0.000description1
- 239000008194pharmaceutical compositionSubstances0.000description1
- 229950005134polycarbophilDrugs0.000description1
- 229920000642polymerPolymers0.000description1
- 229920001343polytetrafluoroethylenePolymers0.000description1
- 239000004810polytetrafluoroethyleneSubstances0.000description1
- 239000000047productSubstances0.000description1
- 230000001737promoting effectEffects0.000description1
- 230000001105regulatory effectEffects0.000description1
- 230000002441reversible effectEffects0.000description1
- 230000000276sedentary effectEffects0.000description1
- 229940124513senna glycosideDrugs0.000description1
- 239000007787solidSubstances0.000description1
- UQZIYBXSHAGNOE-XNSRJBNMSA-NstachyoseChemical compoundO[C@H]1[C@H](O)[C@@H](CO)O[C@@]1(CO)O[C@@H]1[C@H](O)[C@@H](O)[C@H](O)[C@@H](CO[C@@H]2[C@@H]([C@@H](O)[C@@H](O)[C@@H](CO[C@@H]3[C@@H]([C@@H](O)[C@@H](O)[C@@H](CO)O3)O)O2)O)O1UQZIYBXSHAGNOE-XNSRJBNMSA-N0.000description1
- 239000013589supplementSubstances0.000description1
- 230000002195synergetic effectEffects0.000description1
- 229940126585therapeutic drugDrugs0.000description1
- 235000019166vitamin DNutrition0.000description1
- 239000011710vitamin DSubstances0.000description1
- 150000003710vitamin D derivativesChemical class0.000description1
- 229940046008vitamin dDrugs0.000description1
- 239000000811xylitolSubstances0.000description1
- 235000010447xylitolNutrition0.000description1
- HEBKCHPVOIAQTA-SCDXWVJYSA-NxylitolChemical compoundOC[C@H](O)[C@@H](O)[C@H](O)COHEBKCHPVOIAQTA-SCDXWVJYSA-N0.000description1
- 229960002675xylitolDrugs0.000description1
Images
Classifications
- A—HUMAN NECESSITIES
- A61—MEDICAL OR VETERINARY SCIENCE; HYGIENE
- A61K—PREPARATIONS FOR MEDICAL, DENTAL OR TOILETRY PURPOSES
- A61K9/00—Medicinal preparations characterised by special physical form
- A61K9/48—Preparations in capsules, e.g. of gelatin, of chocolate
- A61K9/4808—Preparations in capsules, e.g. of gelatin, of chocolate characterised by the form of the capsule or the structure of the filling; Capsules containing small tablets; Capsules with outer layer for immediate drug release
- A—HUMAN NECESSITIES
- A61—MEDICAL OR VETERINARY SCIENCE; HYGIENE
- A61K—PREPARATIONS FOR MEDICAL, DENTAL OR TOILETRY PURPOSES
- A61K31/00—Medicinal preparations containing organic active ingredients
- A61K31/70—Carbohydrates; Sugars; Derivatives thereof
- A61K31/715—Polysaccharides, i.e. having more than five saccharide radicals attached to each other by glycosidic linkages; Derivatives thereof, e.g. ethers, esters
- A61K31/716—Glucans
- A61K31/717—Celluloses
- A—HUMAN NECESSITIES
- A61—MEDICAL OR VETERINARY SCIENCE; HYGIENE
- A61K—PREPARATIONS FOR MEDICAL, DENTAL OR TOILETRY PURPOSES
- A61K47/00—Medicinal preparations characterised by the non-active ingredients used, e.g. carriers or inert additives; Targeting or modifying agents chemically bound to the active ingredient
- A61K47/06—Organic compounds, e.g. natural or synthetic hydrocarbons, polyolefins, mineral oil, petrolatum or ozokerite
- A61K47/08—Organic compounds, e.g. natural or synthetic hydrocarbons, polyolefins, mineral oil, petrolatum or ozokerite containing oxygen, e.g. ethers, acetals, ketones, quinones, aldehydes, peroxides
- A61K47/12—Carboxylic acids; Salts or anhydrides thereof
- A—HUMAN NECESSITIES
- A61—MEDICAL OR VETERINARY SCIENCE; HYGIENE
- A61K—PREPARATIONS FOR MEDICAL, DENTAL OR TOILETRY PURPOSES
- A61K9/00—Medicinal preparations characterised by special physical form
- A61K9/06—Ointments; Bases therefor; Other semi-solid forms, e.g. creams, sticks, gels
- A—HUMAN NECESSITIES
- A61—MEDICAL OR VETERINARY SCIENCE; HYGIENE
- A61K—PREPARATIONS FOR MEDICAL, DENTAL OR TOILETRY PURPOSES
- A61K9/00—Medicinal preparations characterised by special physical form
- A61K9/48—Preparations in capsules, e.g. of gelatin, of chocolate
- A61K9/4841—Filling excipients; Inactive ingredients
- A61K9/4858—Organic compounds
- A—HUMAN NECESSITIES
- A61—MEDICAL OR VETERINARY SCIENCE; HYGIENE
- A61P—SPECIFIC THERAPEUTIC ACTIVITY OF CHEMICAL COMPOUNDS OR MEDICINAL PREPARATIONS
- A61P1/00—Drugs for disorders of the alimentary tract or the digestive system
- A61P1/10—Laxatives
Landscapes
- Health & Medical Sciences (AREA)
- Chemical & Material Sciences (AREA)
- Life Sciences & Earth Sciences (AREA)
- Animal Behavior & Ethology (AREA)
- Veterinary Medicine (AREA)
- Medicinal Chemistry (AREA)
- Public Health (AREA)
- General Health & Medical Sciences (AREA)
- Pharmacology & Pharmacy (AREA)
- Epidemiology (AREA)
- Engineering & Computer Science (AREA)
- Chemical Kinetics & Catalysis (AREA)
- General Chemical & Material Sciences (AREA)
- Bioinformatics & Cheminformatics (AREA)
- Organic Chemistry (AREA)
- Nuclear Medicine, Radiotherapy & Molecular Imaging (AREA)
- Oil, Petroleum & Natural Gas (AREA)
- Molecular Biology (AREA)
- Medicinal Preparation (AREA)
Abstract
Description
Technical Field
The invention belongs to the technical field of medical assistance, and particularly relates to hydrogel with a function of relaxing bowels, and a preparation method and application thereof.
Background
In modern society, constipation is a common intestinal health problem, which is often manifested by dry stools, difficulty in defecation, and reduced stool weight and frequency. Functional constipation is easily caused by bad habits of modern urban residents such as sedentary, irregular three meals, monophagia and the like. Functional constipation refers to chronic constipation with a lack of organic etiology, no structural abnormalities or metabolic disorders, and no irritable bowel syndrome. Because patients with functional constipation do not have direct focus, people are difficult to adjust living habits due to fast-paced life, and suffer from constipation for a long time. The increase of people suffering from constipation also leads to the rapid development of health-care food and therapeutic drugs with the function of relaxing the bowels.
Researchers have developed various health foods or medicines having a function of relaxing bowels. For example, chinese patent 201310015844 discloses a health food with laxative effect prepared from Chinese herbal medicines as main raw materials, which comprises radix scrophulariae, radix astragali, radix Ophiopogonis, semen Raphani, folium sennae, and stachyose, and combines the characteristics of traditional Chinese herbal medicines with the modern medical research, so that various components can be reasonably combined and used together, and the laxative health food can be used for laxative effect in multiple ways and at multiple levels. Chinese patent 201510042551 discloses a health food with laxative function, which comprises folium sennae extract, semen plantaginis, xylitol, hydroxypropyl methylcellulose and adjuvants, and has synergistic effect of water absorption and swelling property, forms viscous fluid mass in intestinal tract, makes feces in large intestine swell and soften, and easily discharges, stimulates intestinal tract peristalsis, improves intestinal tract function, and has effects of loosening bowel, relieving constipation, and relieving constipation. Chinese patent 201410574477 discloses a food with intestine-propelling promoting effect, which is prepared from fructus Momordicae Charantiae, folium Nelumbinis, semen Cassiae, folium Camelliae sinensis, Glycyrrhrizae radix, bamboo shoot, and brown rice, and has regulating effect on constipation and various macula, acne, pimple, and chloasma caused by long-term constipation, and can be used for a long time. Chinese patent 201510437623 discloses a pharmaceutical composition for treating intestinal diseases, which takes calcium polycarbophil as the main effective component. The calcium polycarbophil is a water-absorbing high-molecular polymer, and is decalcified in a gastric acid environment to generate polycarbophil which can absorb water and swell in intestinal tracts, keep reasonable water in the intestinal tracts and stimulate colon peristalsis, so that defecation is realized.
At present, common health-care food or medicine with the function of relaxing bowels mostly takes excretion-stimulating components such as rhubarb, senna leaf and the like as main functional raw materials, and dependence is generated and intestinal dysfunction is caused after long-term taking. Plantain seed, hydroxypropyl methyl cellulose and other components have water absorption swelling property, can form mucus masses in intestinal tracts, so that excrement is swelled and softened, but the moisture of the excrement is easily absorbed by the large intestine again, the effect is reduced, and the non-crosslinked swelling rate is low, so that the expected effect can be obtained only by taking a large dose. The decalcification of calcium polycarbophil in gastric acid environment can increase the kidney burden of a patient taking the medicine, the hypercalcemia can be easily caused when the medicine is taken by the patient who takes active vitamin D or is easy to suffer from hypercalcemia, the medicine effect is difficult to exert when the patient with gastric acid deficiency takes the medicine, meanwhile, water absorbed during water absorption and expansion is finally discharged out of the body along with excrement, and the patient taking the medicine must supplement water in time.
Therefore, there is a need to develop a product with better defecation effect, safety and no side effect, and does not affect the water absorption of human body.
Disclosure of Invention
In order to solve the defects in the prior art, the invention aims to provide the hydrogel with the function of relaxing bowels, and the preparation method and the application thereof.
In order to achieve the above object, in a first aspect, the present invention provides a hydrogel with a bowel relaxing function, which is formed by cross-linking the following raw materials in parts by weight: 100 parts of sodium carboxymethylcellulose and 0.5-3 parts of polycarboxylic acid; wherein the substitution Degree (DS) of the sodium carboxymethyl cellulose is 0.7-1.2, and the viscosity of the aqueous solution with the mass concentration of 1% prepared by the sodium carboxymethyl cellulose (namely, the sodium carboxymethyl cellulose is dissolved in water to obtain the aqueous solution with the mass concentration of 1% of the sodium carboxymethyl cellulose, the same is applied below) at 25 ℃ is 1500-5000mPa & s; the crosslinking temperature is 100-140 ℃, and the crosslinking time is 5-30 min.
A hydrogel has a three-dimensional network structure between a liquid and a solid, and is a hydrophilic polymer that swells significantly in water but is insoluble in water. The hydrogel forms a physical crosslinking site through a hydrogen bond, and forms a chemical crosslinking site through the condensation reaction of carboxyl on polycarboxylic acid, carboxyl on sodium carboxymethyl cellulose and hydroxyl on sodium carboxymethyl cellulose, so as to form a three-dimensional network structure. When the hydrogel of the invention is in an acidic (such as gastric juice) or neutral (such as intestinal juice) environment, carboxyl ions (-COO) generated by dissociation of sodium carboxymethyl cellulose and unreacted polycarboxylic acid-) H ionized by acids in the environment+The hydrogel is sealed into carboxyl (-COOH), physical cross-linking points are formed in the hydrogel through the action of hydrogen bonds to form a three-dimensional network structure, and the hydrogel and the chemical cross-linking points form a hydrogel three-dimensional network and maintain a high swelling state; when it enters the alkaline colonic environment (e.g., colonic fluid), it is due to H+Reduced, total dissociation of carboxyl groups into carboxyl ions (-COO)-) The hydrogel loses physical cross-linking points formed by hydrogen bonds, and meanwhile, the alkaline environment is favorable for ester group hydrolysis, so that the hydrogel loses chemical cross-linking points, gradually collapses, and finally is completely dissolved after 12-48h, the hydrogel slowly releases water in the process, and the colon environment is kept to continuously have free water, thereby achieving the effect of continuously relaxing the bowels.
In addition, the hydrogel of the present invention must be prepared by strictly controlling the temperature and time of the crosslinking reaction to prevent excessive crosslinking, which results in poor swelling properties of the hydrogel in gastric juice and intestinal juice and poor collapse properties in colonic fluid.
As a preferred embodiment of the hydrogel of the present invention, the crosslinking temperature is 120 ℃ and the crosslinking time is 15 min. When the crosslinking reaction is carried out under the specific condition, the obtained hydrogel not only has very high swelling degree in gastric juice and small intestinal juice, but also cannot absorb and swell after entering colon fluid, and can continuously release water within 48 hours and finally completely disintegrate and dissolve, thereby being more beneficial to the defecation of the colon.
As a preferred embodiment of the hydrogel of the present invention, the substitution degree of the sodium carboxymethylcellulose is 0.9, and the viscosity of an aqueous solution prepared from the sodium carboxymethylcellulose and having a mass concentration of 1% at 25 ℃ is 2500-4500 mPas.
In a preferred embodiment of the hydrogel of the present invention, the polycarboxylic acid is at least one of malic acid, citric acid, tartaric acid, succinic acid, and fumaric acid.
As a preferred embodiment of the hydrogel of the present invention, the polycarboxylic acid is malic acid.
As a preferred embodiment of the hydrogel of the present invention, the weight ratio of the sodium carboxymethyl cellulose to the malic acid is sodium carboxymethyl cellulose: malic acid is 100: 1. in this specific ratio, the resultant hydrogel is more swellable in gastric juice and intestinal juice and more disintegrative and soluble in colon.
In a second aspect, the present invention provides a method for preparing the above hydrogel, comprising the following steps:
(1) dissolving polycarboxylic acid in water to obtain a solution;
(2) adding sodium carboxymethylcellulose while stirring the solution, and then stirring until the sodium carboxymethylcellulose is completely and uniformly dissolved to obtain a micelle;
(3) and drying the micelle for 5-30min at the temperature of 100-140 ℃ to generate a crosslinking reaction, thus obtaining the hydrogel.
As a preferred embodiment of the preparation method of the present invention, a step a is further included between the step (2) and the step (3): drying the micelle at a temperature below 50 ℃. When the drying temperature exceeds 50 ℃, the moisture on the outer side of the micelle evaporates too fast, and the formation of a dry and dense shell can hinder the evaporation of the moisture of the micelle.
As a more preferable embodiment of the preparation method of the present invention, a step a is further included between the step (2) and the step (3): drying the micelle at 40-50 ℃ until the water content is 50-90%, then cutting the micelle into micelles with smaller volume, and continuously drying the micelles for more than 12h at 40-50 ℃ to ensure that the water is basically evaporated and then crosslinking is carried out, which is beneficial to the reversible reaction to advance towards the condensation reaction. Wherein the micelle is dried at 40-50 ℃ to a water content of 50-90%, typically for 4-8 h.
As a preferred embodiment of the preparation method of the invention, the pure water in the step (1) is 15-25 times of the sodium carboxymethyl cellulose.
As a preferred embodiment of the preparation method of the present invention, the preparation method further comprises the steps of: and (4) grinding and screening the hydrogel obtained in the step (3) to obtain dry hydrogel particles with the particle size not more than 2 mm.
In a third aspect, the invention also provides a hydrogel capsule with a function of relaxing bowels, which comprises a gastric-soluble or enteric-soluble capsule shell and contents in the capsule shell, wherein the contents comprise the hydrogel, and the hydrogel is dry particles. After the hydrogel capsule is swallowed, the capsule shell is dissolved in the stomach and intestine, dry hydrogel particles in the capsule swell when contacting liquid, the size is rapidly increased, the hydrogel after water absorption enters an alkaline colon environment and is hydrolyzed to gradually disperse and release water, and finally the hydrogel is completely dissolved after 12 to 48 hours, the water is slowly released by the hydrogel in the process, and the free water is kept in the colon environment continuously, so that the effect of continuously relaxing the bowel is achieved.
As a preferred embodiment of the hydrogel capsule of the present invention, the hydrogel is a particle having a particle size of not more than 2 mm. When the hydrogel particle size is not more than 2mm, the swelling property in gastric juice and small intestinal juice is better, and the collapsibility and solubility in colonic fluid are better.
Compared with the prior art, the invention has the following advantages: according to the invention, the sodium carboxymethyl cellulose is subjected to self-crosslinking reaction at high temperature and crosslinking reaction with the crosslinking agent polycarboxylic acid to form the slightly crosslinked hydrogel, the hydrogel has pH sensitivity, can swell in acidic gastric juice and neutral small intestine liquid, can be completely dispersed and dissolved after 12-48h after entering an alkaline colon environment, can slowly release water during the process, and keeps free water in the colon environment, so that the effect of continuously relaxing the bowels is achieved.
Drawings
FIG. 1 is a graph of the effect of crosslinking temperature on hydrogel swelling ratio;
FIG. 2 is a graph of the effect of cross-linking time on hydrogel swelling ratio;
FIG. 3 is a photograph of a hydrogel obtained according to the present invention;
FIG. 4 is a photograph of the hydrogel obtained by crosslinking for 1 hour or more.
Detailed Description
To better illustrate the objects, aspects and advantages of the present invention, the present invention will be further described with reference to specific examples.
Test 1: effect of crosslinking temperature on hydrogel Properties
The raw materials and crosslinking conditions used for each group of hydrogels are shown in table 1(DS represents the degree of substitution, the same applies below), and the preparation method comprises the following steps:
(1) dissolving malic acid in pure water, and stirring for 0.5h to completely dissolve uniformly to obtain a solution;
(2) adding sodium carboxymethylcellulose while stirring the solution obtained in the step (1), and then continuously stirring for 24 hours to ensure that the sodium carboxymethylcellulose is completely and uniformly dissolved to obtain a micelle;
(3) flatly paving the micelle obtained in the step (2) on a clean polytetrafluoroethylene plate, and then drying in an oven at 40 ℃ for 5 hours until the water content is reduced to be within the range of 50-90 wt%;
(4) cutting the micelle obtained in the step (3) into square blocks with the side length of about 1cm, and continuously drying for 24 hours at the temperature of 40-50 ℃;
(5) carrying out a crosslinking reaction at a specific temperature;
(6) and (4) grinding and screening the crosslinking reaction product obtained in the step (5) to obtain dry hydrogel particles with the particle size not more than 2 mm.
TABLE 1
The swelling effect of the hydrogels obtained from each group in different liquid media was evaluated by a swelling test. Referring to the specification of 'Chinese pharmacopoeia' of 2015 edition, artificial gastric juice, artificial small intestine juice and artificial colon juice are prepared, and the specific preparation methods are respectively as follows:
artificial gastric juice: the diluted hydrochloric acid (16.4 mL) was added with about 800mL of water and 10g of pepsin, shaken, and then diluted with water to 1000mL to a final pH of 1.5.
Artificial small intestine liquid: taking 6.8g of monopotassium phosphate, adding 500mL of water for dissolving, and adjusting the pH value to 6.8 by using 0.1mol/L sodium hydroxide solution; taking another 10g of pancreatin, adding a proper amount of water to dissolve the pancreatin, mixing the two solutions, and adding water to dilute the solution to 1000 mL.
Artificial colon liquid: 5.59g of dipotassium phosphate and 0.41g of monopotassium phosphate are taken, water is added for dissolution, the volume is determined to be 1000mL, and 0.1mol/L sodium hydroxide solution is used for adjusting the pH value to 8.4.
Accurately weighing 0.500 +/-0.005 g of each group of dry hydrogel particles respectively, and recording as WDry matterThen putting each hydrogel particle into a flask filled with 500mL of artificial gastric juice, continuously stirring by using a magnetic stirrer under the heating of water bath at 37 ℃, obtaining a hydrogel sample swelled in the artificial gastric juice through suction filtration after the hydrogel is swelled for 90min, and accurately weighing and recording as WStomach (stomach);
Respectively putting hydrogel samples swelled in artificial gastric juice into flasks filled with 500mL of artificial small intestine juice, continuously stirring by using a magnetic stirrer under the heating of water bath at 37 ℃, obtaining the hydrogel samples swelled in the artificial small intestine juice by suction filtration after the hydrogel is swelled for 90min, accurately weighing and recording as WSmall intestine;
Putting the hydrogel sample swelled in the artificial intestinal juice into a flask filled with 500mL of the artificial intestinal juice, continuously stirring by using a magnetic stirrer under the heating of water bath at 37 ℃, respectively obtaining the hydrogel sample swelled in the artificial intestinal juice after 1h, 6h, 12h, 24h and 48h through suction filtration, accurately weighing, and respectively recording as WColon 1h、WColon 6h、WColon 12h、WColon 24h、WColon 48h;
The swelling ratio of the hydrogel was calculated according to the following formula:
swelling ratio Q of hydrogel in artificial gastric juiceStomach (stomach)=WStomach (stomach)/WDry matter;
Swelling ratio Q of hydrogel in artificial small intestine liquidSmall intestine=WSmall intestine/WDry matter;
Swelling ratio Q of hydrogel in artificial colon fluidColon=WColon/WDry matter。
QColon 1h、QColon 6h、QColon 12h、QColon 24h、QColon 48hRespectively with WColon 1h、WColon 6h、WColon 12h、WColon is 24 hours,WColon 48hCorresponding to the above (the same applies below).
The results are shown in Table 2 and FIG. 1.
TABLE 2
| Group of | QStomach (stomach) | QSmall intestine | QColon 1h | QColon 6h | QColon 12h | QColon 24h | QColon 48h |
| A1 | 14.46 | 0 | 0 | 0 | 0 | 0 | 0 |
| B1 | 17.11 | 92.55 | 48.41 | 28.10 | 8.44 | 0 | 0 |
| C | 15.34 | 82.67 | 54.72 | 34.34 | 25.57 | 12.38 | 0 |
| D1 | 12.86 | 40.44 | 51.83 | 47.65 | 34.45 | 24.56 | 0 |
| E1 | 10.97 | 20.47 | 30.43 | 43.21 | 47.47 | 38.14 | 26.89 |
From table 2, when the crosslinking temperature is 90 ℃, the hydrogel is not crosslinked enough due to not reaching the self-crosslinking temperature of the sodium carboxymethyl cellulose, and the hydrogel is dissolved and dispersed in the artificial small intestine solution; when the crosslinking temperature is 100-140 ℃, the crosslinking degree of the hydrogel is proper, the hydrogel has a higher swelling ratio between the artificial gastric juice and the artificial small intestine juice, can be gradually dissolved in the alkaline artificial colon juice and continuously releases water within 48 hours and finally completely collapses, the crosslinking degree of the hydrogel increases along with the increase of the crosslinking temperature, the swelling ratio in acidic and neutral environments is slightly reduced, but the degradation time in the alkaline environment is prolonged, particularly when the crosslinking temperature is 140 ℃, due to the higher crosslinking degree, crosslinking chemical bonds are hydrolyzed at the initial stage in the artificial colon juice, and then further imbibe and expand, and the hydrogel starts to release water after 1 hour; when the crosslinking temperature is 150 ℃, the crosslinking temperature is high, so that the hydrogel is excessively crosslinked, the swelling ratio of the hydrogel in the artificial gastric juice and the artificial small intestine juice is reduced, the hydrogel cannot be completely dissolved in the artificial colon juice, the swelling ratio of the hydrogel in the artificial colon juice is gradually increased due to high crosslinking degree, and the hydrogel continues to absorb liquid in the first 12 hours without releasing water.
Test 2: effect of Cross-linking time on hydrogel Properties
The raw materials and crosslinking conditions used for each set of hydrogels are shown in Table 3, and the preparation method is the same as that of test 1.
TABLE 3
The swelling effect of each of the obtained hydrogels in different liquid media was evaluated by the same swelling test as in test 1, and the results are shown in table 4 and fig. 2.
TABLE 4
| Group of | QStomach (stomach) | QSmall intestine | QColon 1h | QColon 6h | QColon 12h | QColon 24h | QColon 48h |
| A2 | 21.75 | 95.14 | 0 | 0 | 0 | 0 | 0 |
| B2 | 16.74 | 86.33 | 45.14 | 17.76 | 4.44 | 0 | 0 |
| C | 15.34 | 82.67 | 54.72 | 34.34 | 25.57 | 12.38 | 0 |
| D2 | 11.41 | 39.44 | 42.37 | 44.24 | 32.54 | 21.24 | 0 |
| E2 | 10.55 | 37.64 | 48.64 | 49.17 | 37.37 | 28.57 | 4.14 |
As can be seen from Table 4, when the crosslinking time is 1min, the hydrogel is not crosslinked enough, and is rapidly dissolved and dispersed in the artificial colon fluid, so that the water can not be slowly released for a long time; when the crosslinking time is 5-30min, the crosslinking degree is proper, the artificial gastric juice and the artificial small intestine juice have higher swelling ratio, meanwhile, the artificial gastric juice and the artificial small intestine juice can be gradually dissolved in the alkaline artificial colon juice and continuously release water within 48 hours and finally completely break up, the crosslinking degree of the hydrogel is increased along with the extension of the crosslinking time, the swelling ratio in acid and neutral environments is slightly reduced, but the degradation time in the alkaline environment is prolonged, particularly when the crosslinking time is 30min, the obtained hydrogel has higher crosslinking degree, and in the initial stage of the artificial colon juice, crosslinking chemical bonds are hydrolyzed and further absorb and expand, and the water begins to be released after 6 hours; when the crosslinking time is 40min, the hydrogel is excessively crosslinked due to the fact that the crosslinking time exceeds the critical value, the swelling ratio of the hydrogel in artificial gastric juice and artificial small intestine juice is reduced, and the hydrogel cannot be completely dissolved in the artificial colon juice within 48 hours. In addition, the inventor has referred patent CN201780032349.5 at the initial stage of research, but found that when carboxymethylcellulose sodium (with a substitution degree of 0.7-1.2 and a viscosity of 1500-. The hydrogel obtained by the invention is light yellow, and is in a normal hydrogel state after swelling (see figure 3, the left figure is a dry state, and the right figure is a swelling state), the performance of the hydrogel is similar to that of the hydrogel obtained by the patent examples, and the production efficiency is improved.
Test 3
The raw materials and crosslinking conditions used for each set of hydrogels are shown in Table 5, and the preparation methods are the same as those in test 1.
TABLE 5
The swelling effect of each of the obtained hydrogels in different liquid media was evaluated by the same swelling test as in test 1, and the results are shown in Table 6.
TABLE 6
| Group of | QStomach (stomach) | QSmall intestine | QColon 1h | QColon 6h | QColon 12h | QColon 24h | QColon 48h |
| F | 14.67 | 61.24 | 36.57 | 22.34 | 2.42 | 0 | 0 |
| G | 12.32 | 33.74 | 54.33 | 39.85 | 32.67 | 26.64 | 0 |
| H | 13.84 | 51.31 | 45.72 | 31.45 | 24.38 | 2.12 | 0 |
| I | 16.12 | 71.43 | 51.34 | 42.75 | 27.61 | 17.21 | 0 |
The sodium carboxymethylcellulose used in test 1 and test 2 was made by Shanghai Michelin Biochemical technology Ltd, model number C804618; the sodium carboxymethylcellulose used in group F is produced by Shanghai Mielin Biochemical technology limited, and has the model number of C804620; the sodium carboxymethylcellulose used in group G is made by Shanghai Michelin Biochemical technology limited, and has the model number of C804626; the sodium carboxymethylcellulose used in group H is made by Shanghai Michelin Biochemical technology limited, and has the model number of C804622; the sodium carboxymethylcellulose manufacturer adopted by group I is Shanghai Allantin Biotechnology Co., Ltd., type C104978.
Finally, it should be noted that the above embodiments are only used for illustrating the technical solutions of the present invention and not for limiting the protection scope of the present invention, and although the present invention is described in detail with reference to the preferred embodiments, it should be understood by those skilled in the art that modifications or equivalent substitutions can be made on the technical solutions of the present invention without departing from the spirit and scope of the technical solutions of the present invention.
Claims (10)
1. The hydrogel with the function of relaxing the bowels is characterized by being formed by crosslinking the following raw materials in parts by weight: 100 parts of sodium carboxymethylcellulose and 0.5-3 parts of polycarboxylic acid; wherein the substitution degree of the sodium carboxymethyl cellulose is 0.7-1.2, and the viscosity of an aqueous solution with the mass concentration of 1 percent prepared by the sodium carboxymethyl cellulose at 25 ℃ is 1500-5000mPa & s; the crosslinking temperature is 100-140 ℃, and the crosslinking time is 5-30 min.
2. The hydrogel of claim 1, wherein the crosslinking temperature is 120 ℃ and the crosslinking time is 15 min.
3. The hydrogel according to claim 1, wherein the degree of substitution of the sodium carboxymethylcellulose is 0.9, and the viscosity of a 1% by mass aqueous solution prepared from the sodium carboxymethylcellulose at 25 ℃ is 2500-.
4. The hydrogel of claim 2, wherein the polycarboxylic acid is at least one of malic acid, citric acid, tartaric acid, succinic acid, fumaric acid.
5. The hydrogel of claim 3, wherein the polycarboxylic acid is malic acid.
6. The hydrogel according to claim 5, wherein the weight ratio of the sodium carboxymethyl cellulose to the malic acid is sodium carboxymethyl cellulose: malic acid is 100: 1.
7. a process for the preparation of a hydrogel according to any of claims 1 to 6, comprising the steps of:
(1) dissolving polycarboxylic acid in water to obtain a solution;
(2) adding sodium carboxymethylcellulose while stirring the solution, and then stirring until the sodium carboxymethylcellulose is completely and uniformly dissolved to obtain a micelle;
(3) and drying the micelle for 5-30min at the temperature of 100-140 ℃ to generate a crosslinking reaction, thus obtaining the hydrogel.
8. The method according to claim 7, further comprising, between the step (2) and the step (3), a step A of: drying the micelle at a temperature below 50 ℃ until the water content is reduced to 50-90 wt%.
9. A hydrogel capsule having a laxative function, comprising a gastro-soluble or enteric capsule shell and contents within the capsule shell, the contents comprising the hydrogel of any one of claims 1 to 6, the hydrogel being in the form of dry particles.
10. The hydrogel capsule according to claim 9, wherein the hydrogel has a particle size of not more than 2 mm.
Priority Applications (1)
| Application Number | Priority Date | Filing Date | Title |
|---|---|---|---|
| CN202011207960.7ACN112263563A (en) | 2020-11-03 | 2020-11-03 | Hydrogel with bowel relaxing function and preparation method and application thereof |
Applications Claiming Priority (1)
| Application Number | Priority Date | Filing Date | Title |
|---|---|---|---|
| CN202011207960.7ACN112263563A (en) | 2020-11-03 | 2020-11-03 | Hydrogel with bowel relaxing function and preparation method and application thereof |
Publications (1)
| Publication Number | Publication Date |
|---|---|
| CN112263563Atrue CN112263563A (en) | 2021-01-26 |
Family
ID=74345496
Family Applications (1)
| Application Number | Title | Priority Date | Filing Date |
|---|---|---|---|
| CN202011207960.7APendingCN112263563A (en) | 2020-11-03 | 2020-11-03 | Hydrogel with bowel relaxing function and preparation method and application thereof |
Country Status (1)
| Country | Link |
|---|---|
| CN (1) | CN112263563A (en) |
Cited By (5)
| Publication number | Priority date | Publication date | Assignee | Title |
|---|---|---|---|---|
| CN113854567A (en)* | 2021-09-28 | 2021-12-31 | 至睿生物(江苏)有限公司 | Edible hydrogel, preparation method and application thereof, and intragastric filler comprising edible hydrogel |
| CN114381044A (en)* | 2021-12-16 | 2022-04-22 | 佑道(天津)健康咨询有限公司 | Glucomannan hydrogel powder and preparation method and application thereof |
| CN116162289A (en)* | 2022-12-06 | 2023-05-26 | 四川兴泰普乐医疗科技有限公司 | Multiple crosslinked sodium carboxymethyl cellulose gel, preparation method and application |
| CN118436071A (en)* | 2024-07-08 | 2024-08-06 | 浙江衡美健康科技股份有限公司 | A hydrogel for controlling diet and inducing satiety, and preparation method and application thereof |
| CN120346238A (en)* | 2025-06-20 | 2025-07-22 | 中国医学科学院放射医学研究所 | Multifunctional microgel for delivering probiotics and preparation method and application thereof |
Citations (4)
| Publication number | Priority date | Publication date | Assignee | Title |
|---|---|---|---|---|
| CN101796075A (en)* | 2007-08-10 | 2010-08-04 | 亚历山德罗·圣尼诺 | Polymer hydrogel and its preparation method |
| JP2013071107A (en)* | 2011-09-29 | 2013-04-22 | Kanichi Adachi | Excrement treating agent |
| CN103917092A (en)* | 2011-06-07 | 2014-07-09 | 万有限责任公司 | Methods of producing hydrogels |
| CN109562069A (en)* | 2016-04-25 | 2019-04-02 | 吉莱斯公司 | The method for treating constipation |
- 2020
- 2020-11-03CNCN202011207960.7Apatent/CN112263563A/enactivePending
Patent Citations (4)
| Publication number | Priority date | Publication date | Assignee | Title |
|---|---|---|---|---|
| CN101796075A (en)* | 2007-08-10 | 2010-08-04 | 亚历山德罗·圣尼诺 | Polymer hydrogel and its preparation method |
| CN103917092A (en)* | 2011-06-07 | 2014-07-09 | 万有限责任公司 | Methods of producing hydrogels |
| JP2013071107A (en)* | 2011-09-29 | 2013-04-22 | Kanichi Adachi | Excrement treating agent |
| CN109562069A (en)* | 2016-04-25 | 2019-04-02 | 吉莱斯公司 | The method for treating constipation |
Cited By (6)
| Publication number | Priority date | Publication date | Assignee | Title |
|---|---|---|---|---|
| CN113854567A (en)* | 2021-09-28 | 2021-12-31 | 至睿生物(江苏)有限公司 | Edible hydrogel, preparation method and application thereof, and intragastric filler comprising edible hydrogel |
| CN114381044A (en)* | 2021-12-16 | 2022-04-22 | 佑道(天津)健康咨询有限公司 | Glucomannan hydrogel powder and preparation method and application thereof |
| CN116162289A (en)* | 2022-12-06 | 2023-05-26 | 四川兴泰普乐医疗科技有限公司 | Multiple crosslinked sodium carboxymethyl cellulose gel, preparation method and application |
| CN116162289B (en)* | 2022-12-06 | 2024-03-15 | 四川兴泰普乐医疗科技有限公司 | Multiple crosslinked sodium carboxymethyl cellulose gel, preparation method and application |
| CN118436071A (en)* | 2024-07-08 | 2024-08-06 | 浙江衡美健康科技股份有限公司 | A hydrogel for controlling diet and inducing satiety, and preparation method and application thereof |
| CN120346238A (en)* | 2025-06-20 | 2025-07-22 | 中国医学科学院放射医学研究所 | Multifunctional microgel for delivering probiotics and preparation method and application thereof |
Similar Documents
| Publication | Publication Date | Title |
|---|---|---|
| CN112263563A (en) | Hydrogel with bowel relaxing function and preparation method and application thereof | |
| CN102362853B (en) | Genipin cross-linked soybean protein based theophylline controlled-release gel preparation and preparation method thereof | |
| Bhatti et al. | Utilization of natural superdisintegrant in mouth dissolving tablet: A simplified review | |
| CN104069228B (en) | A bioadhesive microsphere with core-shell structure and preparation method thereof | |
| TWI236913B (en) | Hydrolyzed cellulose granulations of salts of drugs | |
| CN101147769A (en) | Method for preparing traditional Chinese medicine gel preparation for treating cervical erosion and vaginitis | |
| CN100354003C (en) | Sodium acetylide/ soybean separation protein commixed gel granule preparation method | |
| CN103393612A (en) | Preparation method for enalapril maleate orally disintegrating tablets | |
| CN106309380A (en) | Icariin controlled release microsphere, preparation method thereof and application thereof | |
| CN103191331B (en) | Traditional Chinese medicine composition for treating bronchial asthma in remission stage | |
| CN105832993B (en) | Composition with throat clearing function and preparation method and application thereof | |
| CN101028490A (en) | Chinese medicine for treating acne | |
| CN113413366A (en) | Dry-suspension oral in-situ gel for treating chronic gastritis and preparation method thereof | |
| CN103070842B (en) | Preparation method of miglitol sustained release tablet | |
| CN103386101B (en) | Traditional Chinese medicine preparation for nonspecific cystitis treatment and preparation method thereof | |
| CN103041079B (en) | Preparation method of sugar-free Masu anti-cough compound preparation | |
| JP6446071B2 (en) | Indigestible capsule for delivery of fluid absorbent material | |
| CN1229659A (en) | Chinese medicine for treating ulcer of gastrointestinal tract and its prodn. tech. | |
| CN113603808B (en) | Modified algin, preparation method and application thereof in preparation of medicine for promoting gastrointestinal peristalsis | |
| CN112999192B (en) | Quick-release solid preparation and preparation method thereof | |
| CN108785496A (en) | A kind of canker sore sustained release pad pasting and preparation method thereof | |
| CN107823178A (en) | Treat Niflumic Acid colon targeting preparation of IBS and preparation method thereof | |
| CN101336950A (en) | A kind of oral nano raw Atractylodes macrocephala tablet and its preparation method | |
| CN118903061A (en) | Orally disintegrating film loaded with licorice extract and preparation method thereof | |
| CN118078734A (en) | Stomach-occupied gel and preparation method and application thereof |
Legal Events
| Date | Code | Title | Description |
|---|---|---|---|
| PB01 | Publication | ||
| PB01 | Publication | ||
| SE01 | Entry into force of request for substantive examination | ||
| SE01 | Entry into force of request for substantive examination |